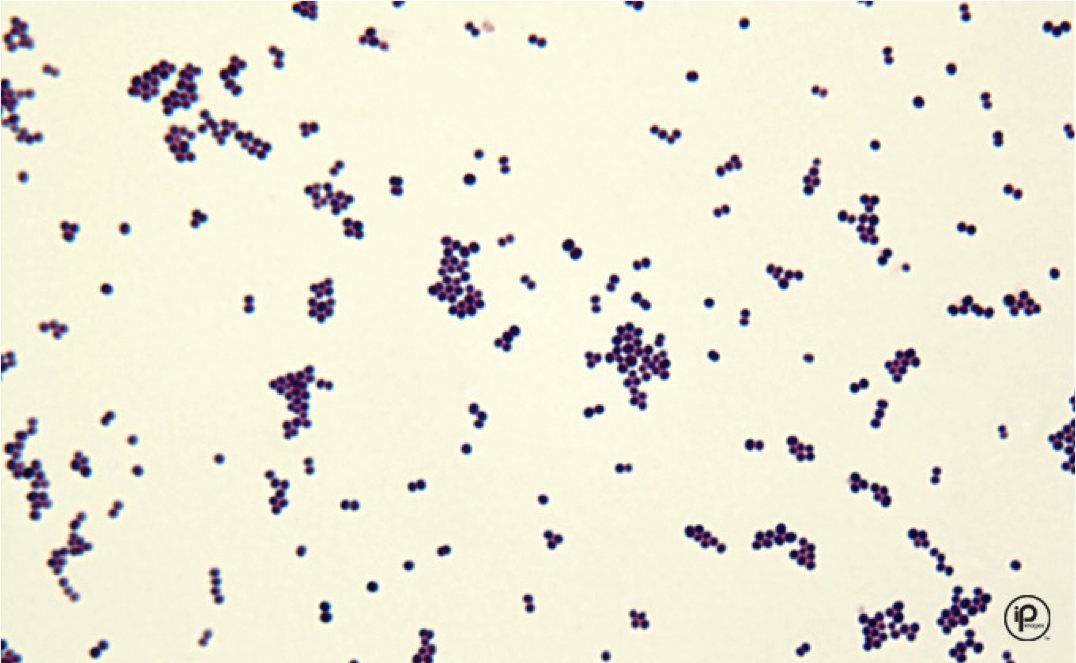
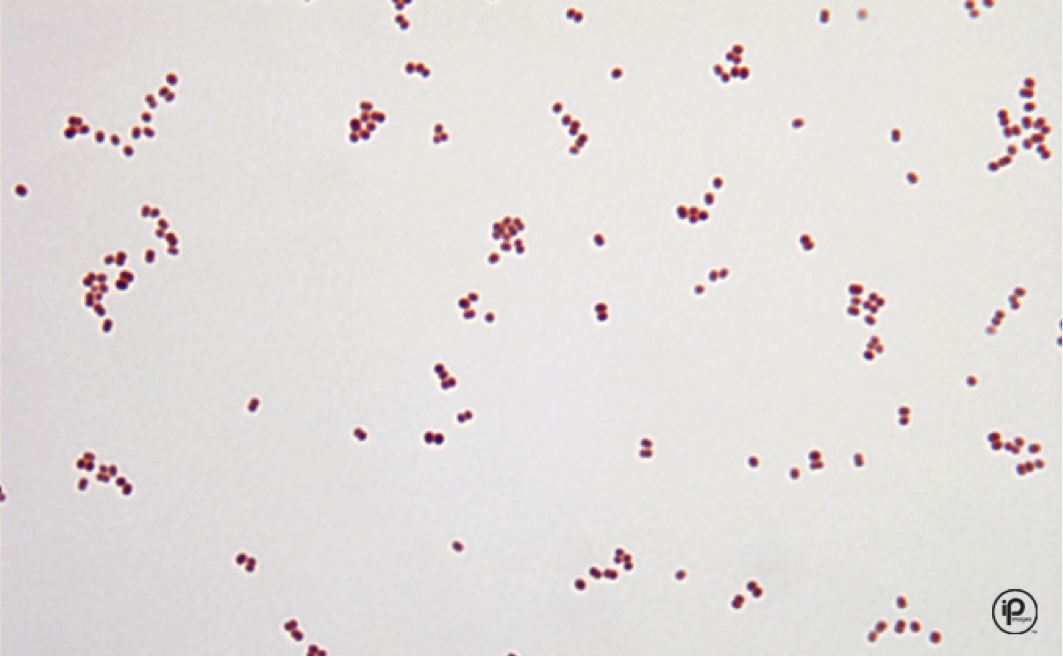

What is the shape of this bacteria? Is it gram positive or gram negative?

Gram positive cocci in pairs
this is pneumococcus
What is the shape of this bacteria? gram positive or negative? What is one organism it could be?

Gram positive cocci in chains
this is group A strep [strep pyogenes]
What is the shape of this bacteria? Gram positive or negative? What kind of bacteria could this be
gram positive cocci in clusters
this is staphylococcus spp
What is the shape of this bacteria? Gram positive or negative?

Gram positive rofds/bacilli
What is the shape? Gram negative or positive? What is an example of what this could be?
Gram negative cocci
this is neisseria spp
What shape? Gram positive or negative? What is an example of what it could be?

Gram negative rods/bacilli
this is campylobacter spp


